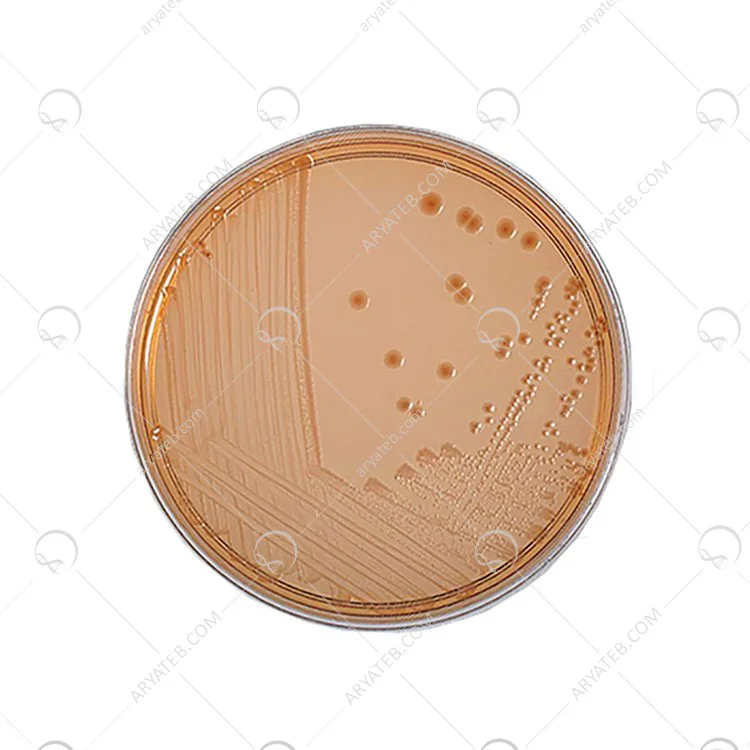

محیط کشت maconkey sorbitol agar
سوربیتول مکانکی آگار یک پاتوژن روده است که به طور عادی باعث کولیت خونریزی شده و باعث مریضی های از جمله اسهال خونی می شود. این بیماری ممکن است به دنبال سندرم اورمیک همولیتیک ، به ویژه در افراد با سن کم و کودکان می باشد. MacConkey Agar با سوربیتول برای جداسازی این ارگانیسم پیشنهاد می شود. راپاپورت و هنیگ برای بار اول فرمول بندی این رسانه را تشریح کردند و بعداً مارس و رثم که MacConkey Agar را با سوربیتول خبر داده بودند تأیید شده است که دارای حساسیت 100٪ و خصوصیات 85٪ هستند. ثابت شده است که این رسانه یک وسیله با قیمت کم، سریع ، ساده ولی قابل اعتماد برای تشخیص E. coli O157: H7 است.
ذخیره سازی: پس از خرید از فروشگاه در دمای 2-8 درجه سانتیگراد و به دور از نور مستقیم نگه داری شود. در صورت وجود علائم وخیم شدن کوچک شدن ، ترک خوردگی یا عوض شدن رنگ ، کثیف شدن ، یا تاریخ انقضاء نباید از رسانه ها استفاده کرد. محصول با وزن کم و حساس به دمای هوا است؛ از نور ، گرمای بیش از حد ، نم و رطوبت و یخ زدگی محافظت کنید
برای دیدن انواع محیط کشت کلیک کنید
طرز تهیه محیط کشت Sorbitol MacConkey agar
- 51.6 گرم مک کانکی سوربیتول آگار را با BCIG در 1 لیتر آب مقطر معلق کنید.
- مخلوط را خوب مخلوط کنید
- سپس در اتوکلاو با دمای 121 درجه سانتیگراد به مدت 15 دقیقه استریل کنید.
- در نهایت، مخلوط را در یک ظرف پتری از ظروف استریل بریزید.
موارد استفاده محیط کشت مک کانکی سوربیتول آگار
- محیط خشک شده را در دمای 30-30 درجه سانتیگراد نگهداری کنید و قبل از تاریخ انقضا روی برچسب استفاده کنید.
- بشقاب های آماده شده را در دمای 8-2 درجه سانتیگراد نگهداری کنید.
آدرس ایمیل شما منتشر نخواهد شد. فیلدهای الزامی علامت گذاری شده اند *